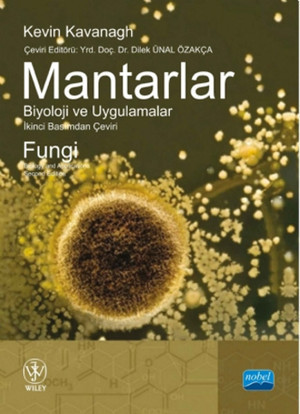

- Popüler Kategoriler
- Oyuncak
- Bebek Sağlık ve Bakım Ürünleri
- Bebek Arabaları
- Ana Kucağı
- Kanguru, Portbebe
- Oto Koltuğu & Aksesuarı
- Bebek Beslenme ve Gereçleri
- Bebek Oyuncakları
- Bebek Odası Mobilya
- Eğitici Oyuncaklar
- Oyun Parkı & Park Yatak
- Hobi, Eğlence
- Bebek Güvenlik
- Bebek Bakım Çantası
- Bebek Bezi ve Islak Mendil
- Parti ve Kutlamalar
- Kedi Mamaları
- Kedi Kumu
- Kedi Oyuncakları
- Kedi Bakım Ürünleri
- Kedi Tırmalama Ürünleri
- Kedi Sağlık Ürünleri
- Kedi Mama ve Su Kapları
- Kedi Ödülleri
- Kedi Tuvalet Kabı ve Aksesuarları
- Kedi Vitaminleri
- Kedi Tasmaları
- Kedi Taşıma ve Seyahat Ürünleri
- Kedi Hijyen ve Bakım Ürünleri
- Kedi Yatakları
- Kedi Evleri
- Kedi Güvenlik Ürünleri
- Kedi Giyim
- Yavru Kedi Bakımı ve Malzemeleri